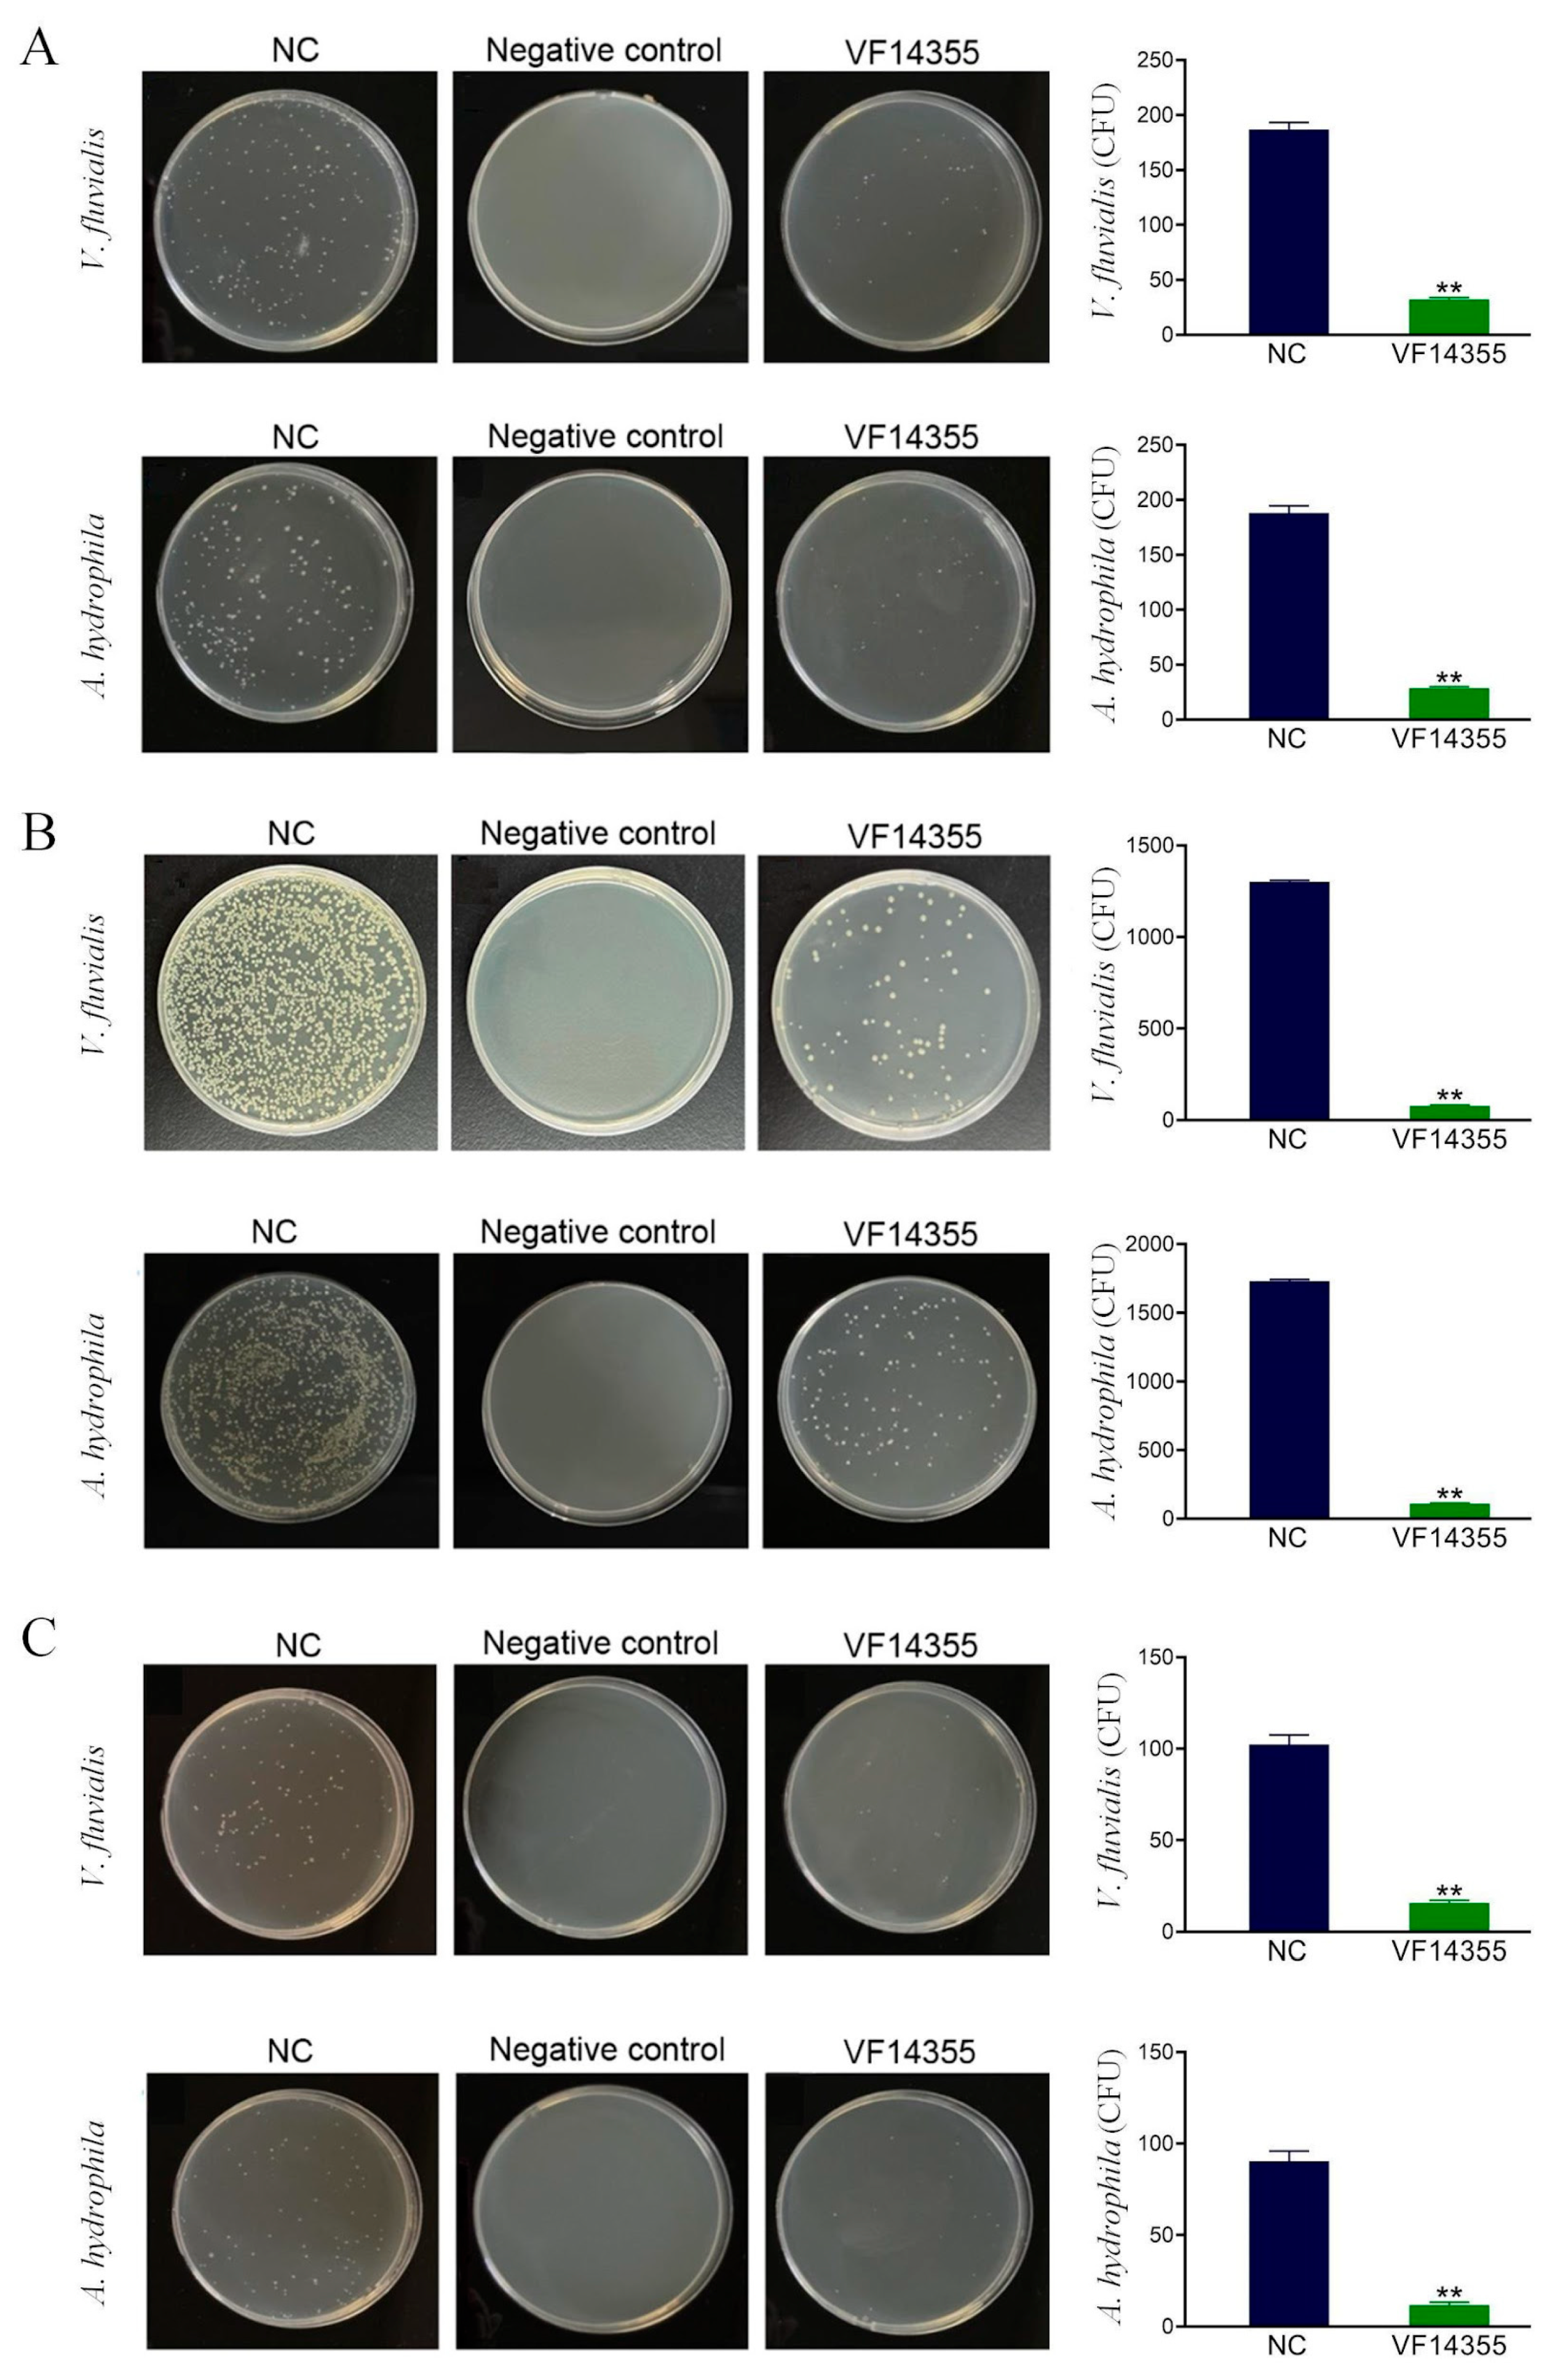
Ijms 26 03379 g002

Evaluation of the Multivalent Immunoprotective Effects of Protein, DNA, and IgY Vaccines Against Vibrio fluvialis Outer Membrane Protein VF14355 in Carassius auratus
Abstract
1. Introduction
2. Results
2.1. Immune Protective Rates of the Protein, IgY, and DNA Vaccines of VF14355
2.2. Detection of the Number of Bacteria in C. auratus Kidneys
2.3. Detection of Plasma Leukocyte Phagocytosis in C. auratus
2.4. Expression of Immune Factors
2.5. Interaction Detection In Vitro
2.6. The Titer and Specificity of VF14355 IgY Antibody
2.7. Detection of Antioxidant-Related Factors in C. auratus Serum
2.8. mRNA Expression of Inflammation Factors in C. auratus
2.9. Histopathological Morphological Observation of C. auratus
2.10. Immunofluorescence Analysis of C. auratus Kidney
3. Discussion
4. Materials and Methods
4.1. Strains and Animals
4.2. Preparation of IgY Antibodies
4.3. Western Blotting
4.4. Interaction Detection In Vitro
4.5. Active Protective and Active Cross-Protective Rates of VF14355
4.6. Passive Protective and Passive Cross-Protective Rates of VF14355 IgY Antibody
4.7. Active Protective and Active Cross-Protective Rates of VF14355 DNA Vaccine
4.8. Immune Factor Detection
4.9. Kidney Bacterial Content
4.10. Leukocyte Phagocytosis Analysis
4.11. Antioxidant Factor Analysis
4.12. mRNA Expression of Inflammatory Factors
4.13. Histopathological Analysis
4.14. Renal Immunofluorescence Analysis
4.15. Statistical Analysis
5. Conclusions
Supplementary Materials
Author Contributions
Funding
Institutional Review Board Statement
Informed Consent Statement
Data Availability Statement
Conflicts of Interest
References
- Roberts, S.; Jacquet, J.; Majluf, P.; Hayek, M.N. Feeding global aquaculture. Sci. Adv. 2024, 10, eadn9698. [Google Scholar] [CrossRef] [PubMed]
- Vandeputte, M.; Kashem, M.A.; Bossier, P.; Vanrompay, D. Vibrio pathogens and their toxins in aquaculture: A comprehensive review. Rev. Aquacult. 2024, 16, 1858–1878. [Google Scholar] [CrossRef]
- Namitha, R.; Abirami, B.; Anoop, B.; Dominic, D.D.; Ameer, A.; Manigundan, K.; Radhakrishnan, M.; Santhiya, P.; Bhaskar, P.V.; Govindaraju, K. Synthesis and characterization of gold nanoparticles using Brevibacterium casei (SOSIST-06) isolated from southern ocean water samples and their in vitro and in silico anti-WSSV activity. Aquaculture 2024, 579, 740205. [Google Scholar] [CrossRef]
- Saleh, A.A.; Mohamed, A.Z.; Elnesr, S.S.; Khafaga, A.F.; Elwan, H.; Abdel-Aziz, M.F.; Khaled, A.A.; Hafez, E.E. Expression and immune response profiles in Nile tilapia (Oreochromis niloticus) and european sea bass (Dicentrarchus labrax) during pathogen challenge and infection. Int. J. Mol. Sci. 2024, 23, 12829. [Google Scholar] [CrossRef]
- Hecht, J.; Borowiak, M.; Fortmeier, B.; Dikou, S.; Gierer, W.; Klempien, I.; Nekat, J.; Schaefer, S.; Strauch, E. Case report: Vibrio fluvialis isolated from a wound infection after a piercing trauma in the baltic sea. Access Microbiol. 2022, 4, 000312. [Google Scholar] [CrossRef]
- Hossain, M.; Ibne Momen, A.M.; Rahman, A.; Biswas, J.; Yasmin, M.; Nessa, J.; Ahsan, C.R. Draft-genome analysis provides insights into the virulence properties and genome plasticity of Vibrio fluvialis organisms isolated from shrimp farms and turag river in bangladesh. Arch. Microbiol. 2022, 204, 527. [Google Scholar] [CrossRef]
- Bao, J.; Guo, D.; Jin, L.; Li, T.; Shi, H. Accurate identification of diverse N-Acyl homoserine lactones in narine Vibrio fluvialis by UHPLC-MS/MS. Curr. Microbiol. 2022, 79, 181. [Google Scholar] [CrossRef]
- Liu, X.; Pan, J.; Gao, H.; Han, Y.; Zhang, A.; Huang, Y.; Liu, P.; Kan, B.; Liang, W. CqsA/LuxS-HapR quorum sensing circuit modulates type VI secretion system VflT6SS2 in Vibrio fluvialis. Emerg. Microbes Infec. 2021, 10, 589–601. [Google Scholar] [CrossRef]
- Arora, H.; McHargue, C. 28353 hemorrhagic cellulitis secondary to Vibrio fluvialis infection. J. Am. Acad. Dermatol. 2021, 85, AB184. [Google Scholar] [CrossRef]
- Noto Guillen, M.; Li, C.; Rosener, B.; Mitchell, A. Antibacterial activity of nonantibiotics is orthogonal to standard antibiotics. Science 2024, 384, 93–100. [Google Scholar] [CrossRef]
- Amábile-Cuevas, C.F.; Lund-Zaina, S. Non-canonical aspects of antibiotics and antibiotic resistance. Antibiotics 2024, 13, 565. [Google Scholar] [CrossRef] [PubMed]
- Cheng, A.V.; Schrank, C.L.; Escobar, I.E.; Mylonakis, E.; Wuest, W.M. Addition of ethylamines to the phenols of bithionol and synthetic retinoids does not elicit activity in gram-negative bacteria. Bioorg. Med. Chem. Lett. 2020, 30, 127099. [Google Scholar] [CrossRef] [PubMed]
- Al Mahmud, A.; Siddiqui, S.A.; Karim, M.R.; Al-Mamun, M.R.; Akhter, S.; Sohel, M.; Hasan, M.; Bellah, S.F.; Amin, M.N. Clinically proven natural products, vitamins and mineral in boosting up immunity: A comprehensive review. Heliyon 2023, 9, e15292. [Google Scholar] [CrossRef]
- Fantoni, G.; Boccadifuoco, G.; Verdirosa, F.; Molesti, E.; Manenti, A.; Montomoli, E. Current challenges and improvements in assessing the immunogenicity of bacterial vaccines. Front. Microbiol. 2024, 15, 1404637. [Google Scholar] [CrossRef] [PubMed]
- Da Costa, R.M.; Rooke, J.L.; Wells, T.J.; Cunningham, A.F.; Henderson, I.R. Type 5 secretion system antigens as vaccines against gram-negative bacterial infections. npj Vaccines 2024, 9, 159. [Google Scholar] [CrossRef]
- Irshath, A.A.; Rajan, A.P.; Vimal, S.; Prabhakaran, V.-S.; Ganesan, R. Bacterial pathogenesis in various fish diseases: Recent advances and specific challenges in vaccine development. Vaccines 2023, 11, 470. [Google Scholar] [CrossRef]
- Mondal, H.; Thomas, J. A review on the recent advances and application of vaccines against fish pathogens in aquaculture. Aquacult. Int. 2022, 30, 1971–2000. [Google Scholar] [CrossRef]
- Wu, X.; Xing, J.; Tang, X.; Sheng, X.; Chi, H.; Zhan, W. Splenic protection network revealed by transcriptome analysis in inactivated vaccine-immunized flounder (Paralichthys olivaceus) against Edwardsiella tarda infection. Front. Immunol. 2022, 13, 1058599. [Google Scholar] [CrossRef]
- Zeng, R.; Pan, W.; Lin, Y.; He, J.; Luo, Z.; Li, Z.; Weng, S.; He, J.; Guo, C. Development of a gene-deleted live attenuated candidate vaccine against fish virus (ISKNV) with low pathogenicity and high protection. Iscience 2021, 24, 102750. [Google Scholar] [CrossRef]
- Kordon, A.O.; Abdelhamed, H.; Ahmed, H.; Park, J.Y.; Karsi, A.; Pinchuk, L.M. Phagocytic and bactericidal properties of channel catfish peritoneal macrophages exposed to Edwardsiella ictaluri live attenuated vaccine and wild-type strains. Front. Microbiol. 2018, 8, 2638. [Google Scholar] [CrossRef]
- Priya, T.J.; Kappalli, S. Modern biotechnological strategies for vaccine development in aquaculture–prospects and challenges. Vaccine 2022, 40, 5873–5881. [Google Scholar] [CrossRef] [PubMed]
- Croucher, N.J. Immune interface interference vaccines: An evolution-informed approach to anti-bacterial Vaccine Design. Microb. Biotechnol. 2024, 17, e14446. [Google Scholar] [CrossRef] [PubMed]
- Chowdhury, S.; Sadhukhan, P.; Mahata, N. Immunoinformatics investigation on pathogenic Escherichia coli proteome to develop an epitope-based peptide vaccine candidate. Mol. Divers. 2024, 1–29. [Google Scholar] [CrossRef] [PubMed]
- He, Q.; Mao, Q.; Peng, X.; He, Z.; Lu, S.; Zhang, J.; Gao, F.; Bian, L.; An, C.; Yu, W. Immunogenicity and protective efficacy of a recombinant protein subunit vaccine and an inactivated vaccine against SARS-CoV-2 variants in non-human primates. Signal Transduct. Target. Ther. 2022, 7, 69. [Google Scholar] [CrossRef]
- Howlader, D.R.; Mandal, R.S.; Lu, T.; Maiti, S.; Dietz, Z.K.; Das, S.; Whittier, S.K.; Nagel, A.C.; Biswas, S.; Varisco, D.J. Development of a nano-emulsion based multivalent protein subunit vaccine against Pseudomonas aeruginosa. Front. Immunol. 2024, 15, 1372349. [Google Scholar] [CrossRef]
- Sun, W.; Rong, N.; Jian, S.; Kang, C.; Chen, C.; Chen, R.; Ding, R.; Chen, C.; Liu, X. Immune responses and protective efficacy of outer membrane protein ExbB of Pseudomonas fluorescens against Aeromonas hydrophila and Pseudomonas fluorescens affecting Carassius auratus. Aquacult. Int. 2021, 29, 2823–2840. [Google Scholar] [CrossRef]
- Tatzber, F.; Wonisch, W.; Resch, U.; Strohmaier, W.; Lindschinger, M.; Mörkl, S.; Cvirn, G. Thinking beyond vaccination: Promising add-on strategies to active immunization and vaccination in pandemics—A mini-review. Viruses 2023, 15, 1372. [Google Scholar] [CrossRef]
- Tammas, I.; Bitchava, K.; Gelasakis, A.I. Transforming aquaculture through vaccination: A review on recent developments and milestones. Vaccines 2024, 12, 732. [Google Scholar] [CrossRef]
- Xu, Z.; Zhang, M.; Zhang, T.; Cui, H.; Li, H.; Wang, X.; Zhao, X.; Chen, X.; Cheng, H.; Xu, J. Immunoprotective efficacy evaluation of OmpTS subunit vaccine against Aeromonas hydrophila infection in Megalobrama amblycephala. Fish Shellfish Immun. 2024, 151, 109665. [Google Scholar] [CrossRef]
- Okamoto, M.; Sasaki, R.; Ikeda, K.; Doi, K.; Tatsumi, F.; Oshima, K.; Kojima, T.; Mizushima, S.; Ikegami, K.; Yoshimura, T. FcRY is a key molecule controlling maternal blood IgY transfer to yolks during egg development in avian species. Front. Immunol. 2024, 15, 1305587. [Google Scholar]
- Pacheco, B.L.B.; Nogueira, C.P.; Venancio, E.J. IgY antibodies from birds: A review on affinity and avidity. Animals 2023, 13, 3130. [Google Scholar] [CrossRef] [PubMed]
- El-Kafrawy, S.A.; Abbas, A.T.; Oelkrug, C.; Tahoon, M.; Ezzat, S.; Zumla, A.; Azhar, E.I. IgY Antibodies: The promising potential to overcome antibiotic resistance. Front. Immunol. 2023, 14, 1065353. [Google Scholar] [CrossRef] [PubMed]
- León-Núñez, D.; Vizcaíno-López, M.F.; Escorcia, M.; Correa, D.; Pérez-Hernández, E.; Gómez-Chávez, F. IgY antibodies as biotherapeutics in biomedicine. Antibodies 2022, 11, 62. [Google Scholar] [CrossRef] [PubMed]
- Zhang, L.; Bai, Y.; Tao, J.; Yang, S.; Tu, C.; Liu, L.; Huang, X.; Li, L.; Qin, Z. Effects of feeding chicken egg yolk antibodies on intestinal cell apoptosis, oxidative stress and microbial flora of tilapia (Oreochromis Niloticus) infected with Streptococcus agalactiae. Fish Shellfish Immun. 2024, 150, 109596. [Google Scholar] [CrossRef]
- Dudley, W.N.; Benuzillo, J.G.; Carrico, M.S. SPSS and SAS programming for the testing of mediation models. Nurs. Res. 2004, 53, 59–62. [Google Scholar] [CrossRef]
- Xiao, H.; Cui, P.; Chen, J.; Han, X.; Ma, Z.; Chen, C.; Liu, Y.; Liu, X. A comparison of polyvalent passive immunoprotection from antibodies with different immunity models of live or inactivated Vibrio fluvialis in fish. Fishes 2024, 9, 302. [Google Scholar] [CrossRef]
- Hokello, J.; Sharma, A.L.; Tyagi, M. An update on the HIV DNA vaccine strategy. Vaccines 2021, 9, 605. [Google Scholar] [CrossRef]
- Pagliari, S.; Dema, B.; Sanchez-Martinez, A.; Zurbia-Flores, G.M.; Rollier, C.S. DNA vaccines: History, molecular mechanisms and future perspectives. J. Mol. Biol. 2023, 435, 168297. [Google Scholar] [CrossRef]
- Wang, C.; Yuan, F. A comprehensive comparison of DNA and RNA vaccines. Adv. Drug Deliver. Rev. 2024, 210, 115340. [Google Scholar] [CrossRef]
- Marsella, A.; Pascoli, F.; Pretto, T.; Buratin, A.; Biasini, L.; Abbadi, M.; Cortinovis, L.; Berto, P.; Manfrin, A.; Vanelli, M. Efficacy of DNA vaccines in protecting rainbow trout against VHS and IHN under intensive farming conditions. Vaccines 2022, 10, 2062. [Google Scholar] [CrossRef]
- Hu, T.; Wang, Y.; Wang, Y.; Cui, H.; Zhang, J.; Chen, H.; Wu, B.; Hao, S.; Chu, C.C.; Wu, Y. Production and evaluation of three kinds of vaccines against Largemouth bass virus, and DNA vaccines show great application prospects. Fish Shellfish Immun. 2024, 153, 109841. [Google Scholar] [CrossRef] [PubMed]
- Zhang, Z.; Chen, G.; Li, N.; Li, Y.; Sirimanapong, W.; Chen, J.; Xia, L. Development and evaluation of immunological effects of a DNA vaccine encoding phosphoketolase family protein against Nocardia seriolae in Hybrid snakehead. Fish Shellfish Immun. 2024, 152, 109773. [Google Scholar] [CrossRef] [PubMed]
- Liu, X.; Rong, N.; Sun, W.; Jian, S.; Chao, J.; Chen, C.; Chen, R.; Ding, R.; Chen, C.; Liu, Y. The identification of polyvalent protective immunogens and immune abilities from the outer membrane proteins of Aeromonas hydrophila in fish. Fish Shellfish Immun. 2022, 128, 101–112. [Google Scholar] [CrossRef] [PubMed]
- Liu, X.; Xiao, H.; Cui, P.; Chen, J.; Chao, J.; Wu, X.; Lu, J.; Zhang, X.; Xu, G.; Liu, Y. Differential polyvalent passive immune protection of egg yolk antibodies (IgY) against live and inactivated Vibrio fluvialis in fish. Fish Shellfish Immun. 2024, 151, 109751. [Google Scholar] [CrossRef]
- Liu, X.; Xiao, H.; Chao, J.; Jian, S.; Wu, X.; Lu, J.; Wang, J.; Chen, C.; Liu, Y. Polyvalent passive vaccine candidates from egg yolk antibodies (IgY) of important outer membrane proteins (PF1380 and ExbB) of Pseudomonas fluorescens in fish. Fish Shellfish Immun. 2023, 143, 109211. [Google Scholar] [CrossRef]
- Liu, X.; Chao, J.; Xiao, H.; Chen, J.; Cui, P.; Wu, X.; Lu, J.; Wang, J.; Chen, C.; Zhang, X. Identification of polyvalent passive vaccine candidates from egg yolk antibodies (IgY) of important outer membrane proteins of Aeromonas hydrophila in fish. Aquacult. Rep. 2024, 35, 102002. [Google Scholar] [CrossRef]

| Gene | NCBI Number | Forward Primer (5–3′) | Reverse Primer (5–3′) |
|---|---|---|---|
| il-6 | XM_026289280.1 | TCTCCTCAGACCCTCAGACG | CGTTTGGTCCCGTGTTTGAC |
| il-8 | XM_026267284.1 | GGAGTGCAGGCCACTGTTAG | ATCAGAAGCATGAAGGCGGA |
| il-1β | AJ249136.1 | TTCAGGAAAGAGACGGGCAC | GTCAGTTGGCACCTGGATCA |
| tnf-α | EU069817.1 | GGGCCACATCGTGATTCGTA | GCCTCCAGTGTAGCATGTGT |
| gapdh | XM_026284269.1 | GATTTCAACGGGGATGTGCG | TCACACACACGGTTGCTGTA |
Disclaimer/Publisher’s Note: The statements, opinions and data contained in all publications are solely those of the individual author(s) and contributor(s) and not of MDPI and/or the editor(s). MDPI and/or the editor(s) disclaim responsibility for any injury to people or property resulting from any ideas, methods, instructions or products referred to in the content. |
© 2025 by the authors. Licensee MDPI, Basel, Switzerland. This article is an open access article distributed under the terms and conditions of the Creative Commons Attribution (CC BY) license (https://creativecommons.org/licenses/by/4.0/).
Share and Cite
Xiao, H.; Chen, J.; Cui, P.; Che, X.; Wu, X.; Lu, J.; Zhu, G.; Liu, Y.; Liu, X. Evaluation of the Multivalent Immunoprotective Effects of Protein, DNA, and IgY Vaccines Against Vibrio fluvialis Outer Membrane Protein VF14355 in Carassius auratus. Int. J. Mol. Sci. 2025, 26, 3379. https://doi.org/10.3390/ijms26073379
Xiao H, Chen J, Cui P, Che X, Wu X, Lu J, Zhu G, Liu Y, Liu X. Evaluation of the Multivalent Immunoprotective Effects of Protein, DNA, and IgY Vaccines Against Vibrio fluvialis Outer Membrane Protein VF14355 in Carassius auratus. International Journal of Molecular Sciences. 2025; 26(7):3379. https://doi.org/10.3390/ijms26073379
Chicago/Turabian StyleXiao, Huihui, Jing Chen, Pan Cui, Xixian Che, Xiaoqing Wu, Juan Lu, Guoping Zhu, Yong Liu, and Xiang Liu. 2025. "Evaluation of the Multivalent Immunoprotective Effects of Protein, DNA, and IgY Vaccines Against Vibrio fluvialis Outer Membrane Protein VF14355 in Carassius auratus" International Journal of Molecular Sciences 26, no. 7: 3379. https://doi.org/10.3390/ijms26073379
APA StyleXiao, H., Chen, J., Cui, P., Che, X., Wu, X., Lu, J., Zhu, G., Liu, Y., & Liu, X. (2025). Evaluation of the Multivalent Immunoprotective Effects of Protein, DNA, and IgY Vaccines Against Vibrio fluvialis Outer Membrane Protein VF14355 in Carassius auratus. International Journal of Molecular Sciences, 26(7), 3379. https://doi.org/10.3390/ijms26073379
